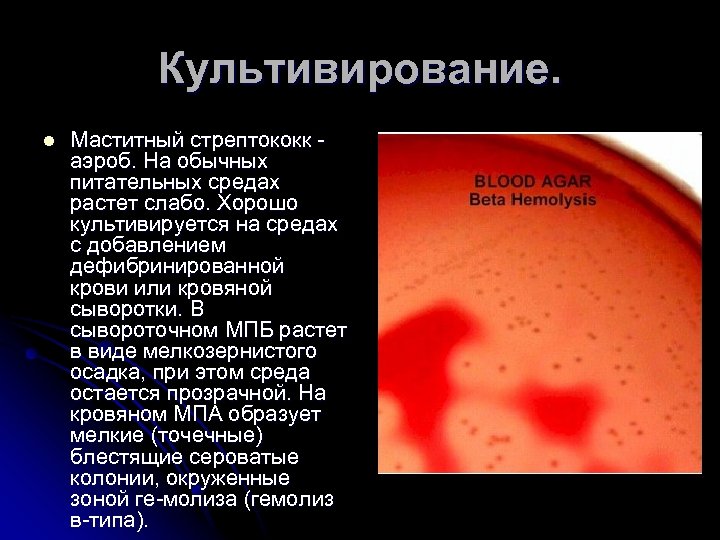

Культивирования стрептококков
Культивирования стрептококков 111 фото
Прорыв хоккей нижний новгород 2015
Погода в весьегонске на неделю 7 дней
Расписание несета минск
Температура нептуна ночью
Адепт круга хранителей
Расписание трамваев нижний 8 выходные от увз
Волк воющий тату значение
Новости славянска на кубани 27 апреля
Чем лечить аллергию на гель
Стажировка проблемы